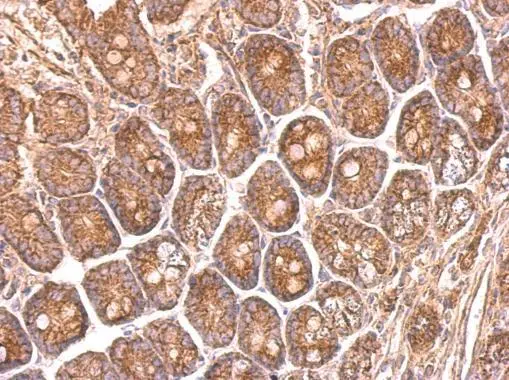
NDUFS8 antibody detects NDUFS8 protein at on mouse intestine by immunohistochemical analysis. Sample: Paraffin-embedded mouse intestine. NDUFS8 antibody (GTX114119) dilution: 1:500. 
 Antigen Retrieval: Trilogy? (EDTA based, pH 8.0) buffer, 15min

NDUFS8 antibody detects NDUFS8 protein at on mouse stomach by immunohistochemical analysis. Sample: Paraffin-embedded mouse stomach. NDUFS8 antibody (GTX114119) dilution: 1:500.
Antigen Retrieval: Trilogy? (EDTA based, pH 8.0) buffer, 15min
NDUFS8 antibody
GTX114119
ApplicationsWestern Blot, ImmunoHistoChemistry, ImmunoHistoChemistry Paraffin
Product group Antibodies
ReactivityHuman, Mouse, Rat
TargetNDUFS8
Overview
- SupplierGeneTex
- Product NameNDUFS8 antibody
- Delivery Days Customer9
- Application Supplier NoteWB: 1:500-1:3000. IHC-P: 1:100-1:1000. *Optimal dilutions/concentrations should be determined by the researcher.Not tested in other applications.
- ApplicationsWestern Blot, ImmunoHistoChemistry, ImmunoHistoChemistry Paraffin
- CertificationResearch Use Only
- ClonalityPolyclonal
- Concentration0.35 mg/ml
- ConjugateUnconjugated
- Gene ID4728
- Target nameNDUFS8
- Target descriptionNADH:ubiquinone oxidoreductase core subunit S8
- Target synonymsCI-23k, CI23KD, MC1DN2, TYKY, NADH dehydrogenase [ubiquinone] iron-sulfur protein 8, mitochondrial, NADH dehydrogenase (ubiquinone) Fe-S protein 8, 23kDa (NADH-coenzyme Q reductase), NADH-ubiquinone oxidoreductase 23 kDa subunit, complex I 23kDa subunit, complex I-23kD
- HostRabbit
- IsotypeIgG
- Protein IDO00217
- Protein NameNADH dehydrogenase [ubiquinone] iron-sulfur protein 8, mitochondrial
- Scientific DescriptionThis gene encodes a subunit of mitochondrial NADH:ubiquinone oxidoreductase, or Complex I, a multimeric enzyme of the respiratory chain responsible for NADH oxidation, ubiquinone reduction, and the ejection of protons from mitochondria. The encoded protein is involved in the binding of two of the six to eight iron-sulfur clusters of Complex I and, as such, is required in the electron transfer process. Mutations in this gene have been associated with Leigh syndrome. [provided by RefSeq]
- ReactivityHuman, Mouse, Rat
- Storage Instruction-20°C or -80°C,2°C to 8°C
- UNSPSC41116161